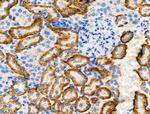
Phospho-NDRG1 (Ser330) Antibody in Immunohistochemistry (Paraffin) (IHC (P))
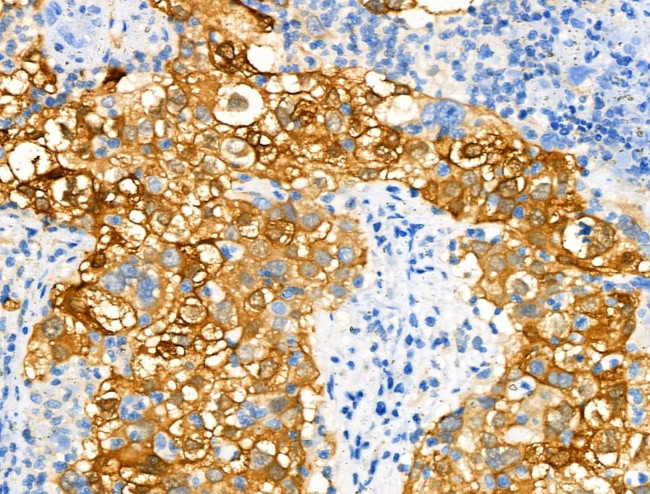
Phospho-NDRG1 (Ser330) Antibody in Immunohistochemistry (Paraffin) (IHC (P))

Search
Invitrogen
Phospho-NDRG1 (Ser330) Polyclonal Antibody
{{$productOrderCtrl.translations['antibody.pdp.commerceCard.promotion.promotions']}}
{{$productOrderCtrl.translations['antibody.pdp.commerceCard.promotion.viewpromo']}}
{{$productOrderCtrl.translations['antibody.pdp.commerceCard.promotion.promocode']}}: {{promo.promoCode}} {{promo.promoTitle}} {{promo.promoDescription}}. {{$productOrderCtrl.translations['antibody.pdp.commerceCard.promotion.learnmore']}}
图: 1 / 4
Phospho-NDRG1 (Ser330) Antibody (PA5-106191) in IHC (P)

Please note: We are reviewing Western blot images included in the antibody testing data in our catalog, including those provided by third parties. Unless expressly labeled or annotated as “raw-unedited”, Western blot images included in the antibody testing data in our catalog may have been edited, optimized or otherwise adjusted for presentation.
产品信息
PA5-106191
种属反应
宿主/亚型
分类
类型
抗原
偶联物
形式
浓度
规格
纯化类型
保存液
内含物
保存条件
运输条件
RRID
产品详细信息
Antibody detects endogenous levels of NDRG1 only when phosphorylated at Ser330.
靶标信息
NDRG1 is a 394 amino acid cytoplasmic protein belonging to the NDRG family. It interacts with APO A-I and A-II and plays a role in HDL-mediated cholesterol transport, stress responses, hormone responses, cell growth and differentiation. Its defect causes Charcot-Marie-Tooth disease type 4D (CMT4D) that is characterized by reduced nerve conduction velocities, segmental demyelination and remyelination with onion bulb formations on nerve biopsy, slowly progressive distal muscle atrophy and weakness, absent deep tendon reflexes and hollow feet. NDRG1 plays a growth inhibitory role and serves as a marker of differentiation. It is expressed in placental membranes, prostate, kidney, small intestine, ovary tissues, colon and the cells that border the lumen.
仅用于科研。不用于诊断过程。未经明确授权不得转售。
篇参考文献 (0)
生物信息学
蛋白别名: Differentiation-related gene 1 protein; DRG-1; N-myc downstream regulated 1; N-myc downstream regulated gene 1; N-myc downstream-regulated gene 1 protein; Nickel-specific induction protein Cap43; Protein Ndr1; Protein NDRG1; Reducing agents and tunicamycin-responsive protein; Rit42; RTP
基因别名: CAP43; CMT4D; DRG1; HMSNL; Ndr1; NDRG1; Ndrl; NMSL; PROXY1; RTP; TDD5
UniProt ID: (Mouse) Q62433, (Rat) Q6JE36
Entrez Gene ID: (Mouse) 17988, (Rat) 299923